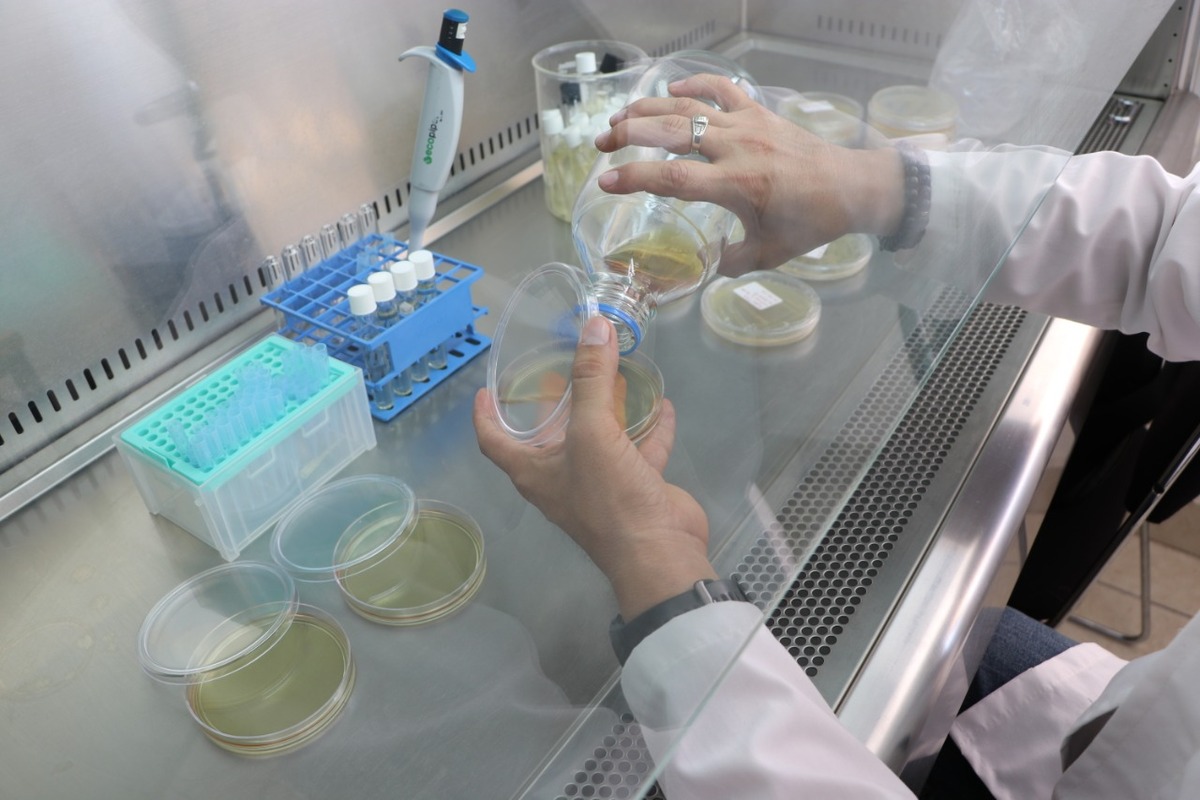

Noticias de 'ug' en Milenio: 405
-
Avelina Lésper presenta su libro 'El fraude del arte contemporáneo' en la UG
 La escritora y crítica de arte se presentó en el marco de la Feria del Libro de la Universidad de Guanajuato.
La escritora y crítica de arte se presentó en el marco de la Feria del Libro de la Universidad de Guanajuato. -
UG cierra el 2022 con 25 delitos cometidos a estudiantes
 La institución reportó hechos delictivos, principalmente asaltos, cometidos a estudiantes.
La institución reportó hechos delictivos, principalmente asaltos, cometidos a estudiantes. -
A nivel internacional, académico de la UG destaca en la investigación de plantas medicinales
 Una de sus líneas de investigación es la “Farmacología de preclínica de productos naturales y evaluación de su mecanismo de acción”.
Una de sus líneas de investigación es la “Farmacología de preclínica de productos naturales y evaluación de su mecanismo de acción”. -
Reconocen a Científicos de la UG por trabajos de investigación
 Fueron reconocidos por la editorial Elsevier y la Universidad de Stanford.
Fueron reconocidos por la editorial Elsevier y la Universidad de Stanford. -
Explora UG aplicaciones de la Ingeniería de Datos y la Inteligencia Artificial
 En el Departamento de Ingeniería Electrónica se han enfocado principalmente en ser los ojos de los sistemas autónomos.
En el Departamento de Ingeniería Electrónica se han enfocado principalmente en ser los ojos de los sistemas autónomos. -
UG obtiene patente por el desarrollo de productos cosméticos antioxidantes
 Esta patente tiene diversos usos potenciales, y virtudes que pueden ser atractivos para la industria.
Esta patente tiene diversos usos potenciales, y virtudes que pueden ser atractivos para la industria. -
Exploran en la UG las telecomunicaciones y la fotónica
 En la Universidad de Guanajuato se generan conocimientos que impactan en la sociedad.
En la Universidad de Guanajuato se generan conocimientos que impactan en la sociedad. -
UG obtiene patente por el proceso de obtención de fibra y cutícula de nopal
En Celaya-Salvatierra se generan productos para la industria a través de la descomposición orgánica del nopal.
En Celaya-Salvatierra se generan productos para la industria a través de la descomposición orgánica del nopal. -
UG responde a problemáticas sociales con su capacidad de investigación
 Tiene el fin de propiciar la generación y la transferencia de conocimiento mediante productos ajustados a los requerimientos del entorno.
Tiene el fin de propiciar la generación y la transferencia de conocimiento mediante productos ajustados a los requerimientos del entorno. -
"Ninguna abeja abandonó la colmena" Pese a pandemia, matrícula de alumnos crece en UG
 En el evento 90 estudiantes lograron reconocimiento a nivel nacional e internacional.
En el evento 90 estudiantes lograron reconocimiento a nivel nacional e internacional.
